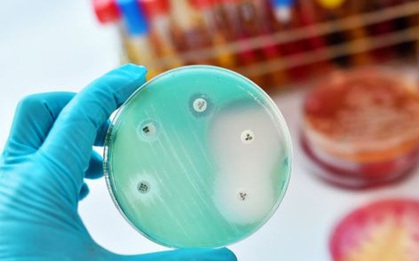

TIN TỨC VỀ kháng sinh - khang sinh
kháng sinh
-
Hiểm họa từ việc người bệnh đang dùng kháng sinh khi mới thấy đỡ đã vội dừng
Kháng sinh từng được xem là “vũ khí cứu mạng” trong điều trị nhiễm trùng. Tuy nhiên, việc lạm dụng và sử dụng sai cách đang khiến loại thuốc này dần mất tác dụng, đẩy nhiều người bệnh vào tình trạng nhiễm trùng kéo dài, điều trị tốn kém, nguy cơ tử vong cao. -
WHO cảnh báo kháng kháng sinh là tình trạng khẩn cấp y tế toàn cầu
Tổ chức Y tế Thế giới (WHO) ngày 18/11 cảnh báo kháng kháng sinh đã và đang gây ra tình trạng khẩn cấp về sức khỏe toàn cầu. -
Người phụ nữ bị lột da toàn thân sau khi sử dụng kháng sinh
Nữ bệnh nhân 67 tuổi mắc hội chứng Lyell, còn gọi là hoại tử thượng bì nhiễm độc toàn thân – TEN, một bệnh lý hiếm gặp có tỷ lệ tử vong rất cao. -
Cảnh báo của bác sĩ về loại kháng sinh nguy hiểm được hàng triệu người sử dụng gây suy nội tạng
Các bác sĩ đang gióng lên hồi chuông cảnh báo về một loại kháng sinh phổ biến được hàng triệu người sử dụng có liên quan đến nhiều ca tử vong và phản ứng cực đoan. -
4 loại thực phẩm là ''kháng sinh tự nhiên'' giúp chống viêm, ngăn ngừa ung thư hiệu quả: Tất cả đều có sẵn ở Việt Nam mà giá lại rẻ bèo
Bổ sung những thực phẩm này vào bữa ăn hàng ngày sẽ giúp tăng cường đề kháng tự nhiên cho cơ thể, đồng thời kéo dài tuổi thọ của bạn và gia đình. -
Cứu sống bé trai 6 tuổi nghi sốc phản vệ kháng sinh
Nhập viện vì viêm phổi tại bệnh viện tuyến dưới, trong quá trình điều trị, bé bị sốc phản vệ nghi do thuốc kháng sinh. -
Tin nổi bật kenh 14
-
Giải pháp "đơn giản" giúp hạn chế tình trạng lạm dụng thuốc kháng sinh ở trẻ
Nhiều bậc phụ huynh thường có tâm lý sử dụng thuốc kháng sinh khi con bị nghẹt mũi, sổ mũi. Tuy nhiên, đây là một sai lầm bởi việc lạm dụng thuốc kháng sinh sẽ gây nên tình trạng kháng thuốc. -
Thói quen nhiều mẹ Việt mắc khiến con ngày càng kháng kháng sinh
Trong điều kiện thời tiết hiện nay, số trẻ mắc các bệnh lý viêm hô hấp trên ngày càng tăng. Tuy nhiên, chuyên gia cảnh báo không phải thấy trẻ chảy mũi, nước mũi xanh là dùng ngay thuốc kháng sinh. -
Trí tuệ nhân tạo vừa tìm ra một loại siêu kháng sinh mới, có thể tiêu diệt vi khuẩn kháng kháng sinh nguy hiểm nhất
Trí tuệ nhân tạo đã giúp các nhà nghiên cứu thực hiện được những điều không tưởng. -
Tin buồn ngày Môi trường thế giới: 2/3 các dòng sông toàn cầu đang “nhiễm độc” thuốc kháng sinh, có nơi cao gấp 300 lần mức tiêu chuẩn
Với các vi khuẩn kháng kháng sinh, đó quả là môi trường lý tưởng để "tôi luyện kỹ năng", phát triển khả năng kháng thuốc, nhưng với con người thì lại là thảm họa.